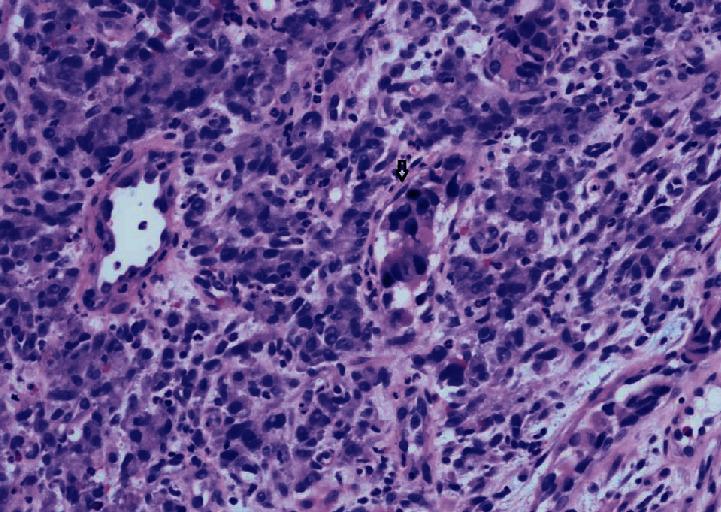
https://cdn.ncbi.nlm.nih.gov/pmc/blobs/4340/7707955/e65490d5d948/CRIONM2020-4150924.004.jpg

良性表现导致肺淋巴管癌病诊断延迟
Delays in Diagnosis of Pulmonary Lymphangitic Carcinomatosis due to Benign Presentation.
作者信息
Pandey Swati, Ojha Shishir
机构信息
Elkhart General Hospital, 600 East Blvd, Elkhart, IN 46514, USA.
Elkhart General Hospital, Beacon Medical Group Pulmonology, 500 Arcade Avenue, Suite 210, Elkhart, IN 46514, USA.
出版信息
Case Rep Oncol Med. 2020 Nov 24;2020:4150924. doi: 10.1155/2020/4150924. eCollection 2020.
The diagnosis of lymphangitic carcinomatosis is challenging due to the manifestation of nonspecific symptoms and radiographic abnormalities that bear similarity to those of interstitial lung disease. Herein, we report the case of a 53-year-old woman diagnosed with lymphangitic carcinomatosis from metastatic gastric adenocarcinoma, 3 months after her initial presentation.
淋巴管癌病的诊断具有挑战性,因为其非特异性症状和影像学异常表现与间质性肺病相似。在此,我们报告一例53岁女性病例,该患者在初次就诊3个月后被诊断为转移性胃腺癌所致的淋巴管癌病。